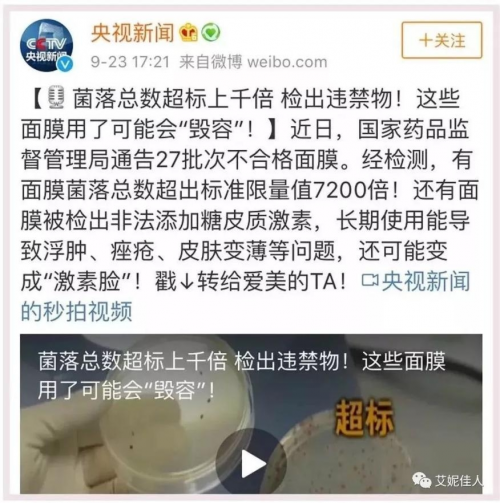

想要给皮肤补水护理皮肤,大家都会选择用面膜,面膜是现如今许多人都离不开的护肤品了。不过,市面上的面膜种类繁多、良莠不齐,加上有些人肤质比较敏感,稍有不慎就会引起皮肤敏感甚至烂脸,所以一定要选择温和无刺激的面膜,才不会伤害皮肤。
这款花希研山茶花精粹焕颜面膜,核心成分都来源于自家的花田,品质和供应都高要求、严标准。而且这款面膜是十大无添加,不含酒精、荧光剂、色素、化学香精、激素、矿物油、重金属、致痘成分以及孕妇禁用成分。不使用尼泊金酯等强刺激性的防腐剂,采用源自植物具有护肤效果的锁鲜体系,更加温和不刺激,对孕妇、哺乳妈妈、敏感肌都很友好。口说无凭,为了让消费者们用的放心,花希研实验室还专门做了皮肤刺激性测试。

现在来看一下花希研山茶花精粹焕颜面膜能不能经得住考验。首先,实验人员挖一勺面膜膏放置在培养皿中,然后取出一片PH试纸,蘸取花希研山茶花精粹焕颜面膜,等待3秒反应后,拿出进行数据对照。


结果显示,花希研山茶花精粹焕颜面膜PH值在5一6之间,和人体皮肤酸碱度相似了,安全温和、不刺激皮肤,也不容易致敏。看完实验后使用是不是更加放心了,毕竟敷在脸上的东西,一定得无伤肌肤。
花希研一直致力于研发亚洲人适用的山茶花护肤品,深度开发山茶花护肤能量,追溯护肤的源头,精心挑选、严格配比,为你带来最有力的安全感和底气。
免责声明:市场有风险,选择需谨慎!此文仅供参考,不作买卖依据。
文章投诉热线:156 0057 2229 投诉邮箱:29132 36@qq.com





